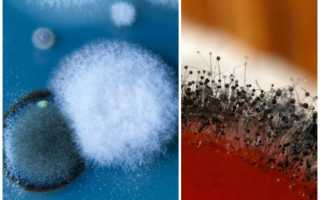

Что такое плесень?
Плесень- это довольно заметный налет, который образуют плесневые грибы. Они буквально вездесущи, растут практически на всех материалах и в любых климатических условиях. Грибок проявляется не только на поверхности предметов или стен, но и микроскопическими нитями проникают внутрь поверхностей, поэтому вывести плесень не всегда легко.
Чаще всего плесень в доме можно разделить на несколько видов:
- Зеленая. Часто она поражает именно продукты питания, расселяясь и заражая еду.
- Белая. Можете встретить в горшках для цветов, на деревянной мебели, хлебе.
- Синева. Поражает оконные рамы, двери, паркетные полы или мебель.
- Черная. Наиболее опасный тип грибка, который появляется повсеместно: кафель в ванной, обои в комнате, стены, потолок.
Плесень в квартире: чем опасна для здоровья
Плесневой гриб наиболее опасен для детей, беременных и пожилых людей. Его споры распространяются по воздуху, заражают новые поверхности, попадают в организм человека.
Наиболее опасна плесень людям с:
- астмой
- аллергией
- пневмонией
- частыми головными болями
- депрессиями
- воспалительными заболеваниями кожи
- и др.
Постоянно пребывая в квартире с плесенью, у человека дольше протекают простуда и Грипп.
Еще плесень вызывает такие серьезные патологии как поражения печени и почек, эмфизему легких.
Многие типы плесени, распространенные на территории стран СНГ, являются патогенными формами, то есть они являются возбудителями различных заболеваний.
Избавиться от плесени в швах санузла несложно, если она не проникла глубоко в структуру швов. Иначе — легче и эффективнее удалить старую затирку и положить новую. Если швы из эпоксидной затирки — плесень им не страшна.
Именно из-за перечисленных выше опасностей, при обнаружении в квартире плесени, стоит самостоятельно приступить к ее удалению или прибегнуть к помощи клинеров.
Причины появления плесени
Плесень в домашних условиях начинает активно размножаться и разрастаться только тогда, когда попадает в подходящую среду.
- Идеальный уровень влажности- 60-80%. Такой уровень может быть в ванной комнате или душевой кабинке.
- Налет выживает как при очень высоких температурах, так и при чрезмерно низких. Наиболее оптимальный интервал от 4 до 20 °C.
- Сложности в циркуляции воздуха: нагроможденная мебель, кучи разношерстных вещей, закрытые окна- воздух все сильнее заражен спорами, и грибку становится значительно проще размножаться.
Что нужно приготовить для успешной борьбы
Перед началом неравного боя с вездесущим грибком, вооружитесь такими средствами:
- Для своей защиты: рукавички, очки, респиратор.
- Для механического удаления: губка, щеточка, тряпка, скребок, наждачная бумага, емкость для воды, моющее или чистящее средство, пакет для мусора.
- Для конечной обработки: лак для дерева, средство, убивающее споры.
- Перед тем, как преступить к обработке, наденьте очки, перчатки, респиратор, не станет лишним и специальный костюм.
Важно! Помните, что вдыхание спор очень вредно для здоровья. Органы дыхания и кожа принимают главный удар. После процедуры вымойте руки и тело. При первых ощущениях недомогания обратитесь к врачу.
Как избавиться от плесени
Плесень в квартире уничтожается по следующему простому алгоритму:
- Механическая чистка пораженной области от появившегося налета.
- Обработка от плесени специальным средством по всей поверхности с захватом близлежащих метров.
- Просушка поверхности и проветривание помещения.
- Недопущение повторного образования налета путем контроля влажности и циркуляции воздуха.
Алгоритм удаления грибка
Для того чтобы удалить грибок, достаточно приобрести в магазине самый обычный уксус и залить его в распылитель. После этого густо нанести продукт на поверхность и подержать его там, в течение двадцати или тридцати минут. По истечении этого времени, продукт необходимо смыть тщательно, просушить поверхность после всех проделанных над ней операций.
- Как удалить грибок с помощью аммиака? Сделать это еще проще, чем с помощью вышеперечисленных средств. Пропорции для раствора таковы: на количество воды размером в два стакана, необходимо добавить два стакана аммиака. После этого нанести этот продукт на зараженную поверхность. Следует обратить особое внимание на безопасность. Несмотря на свою эффективность, аммиак является очень токсичным веществом, поэтому при его использовании необходимо надевать респиратор, специальные очки, резиновые перчатки и защитную одежду. После выполнения процедуры, необходимо на сутки покинуть помещение и тщательно проветрить его, чтобы все токсичные выделения, которые производит аммиак, удалились из воздуха и с поверхности. Несмотря на всю опасность, после выполнения всех действий, можно навсегда забыть про грибок и плесень.
Полезные советы по механическому очищению
- Самое важное- хорошенько убрать видимый налет. Если слой свежий и появился недавно, то ликвидировать плесень со стен можно губкой или щеткой с применением обычного мыльного раствора.
- Выводить плесень с обоев представляется возможным только на первых порах. Если слой въелся, то удалять его нужно, зачищая до штукатурки.
Важно! Нельзя медлить, ведь домашняя плесень буквально за год может проникнуть сквозь штукатурку к бетону и кирпичу.
- В процессе удаления смачивайте стену, это не даст спорам распространяться по воздуху.
- Удалить грибок на стене, выбеленной известью, можно, орудуя скребком или наждачной бумагой. Не забудьте перед началом смочить потолок или стену.
- Плесень в ванной комнате предпочитает селиться в швах между кафелем или в стыках около сантехники. Скребком счистите пораженный участок, пройдитесь по швам наждачкой. Просушите, нанесите дезинфицирующее средство, заново зашейте участки между плитками и стыки герметиком и затиркой.
Важно! Все грязные остатки сразу складывайте в герметичный пакет, а не разбрасывайте по полу. Это не даст грибку в ванне распространиться дальше.
Виды плесени
Разновидностей плесени, которая может образоваться в вашем жилом доме, есть несколько:
- Зеленая плесень – встречается наиболее часто. Ее можно не бояться, поскольку если знать, как правильно устранить плесень с обоев, то она быстро исчезнет.
- Темно-зеленая плесень – более проблематичная, однако удаляется также просто, если ее выявить сразу и начать действовать быстро.
- Белая, на вид как пух плесень – может распространяться почти незаметно. За короткое время ею поражается все помещение. С белым видом точно нельзя медлить, так как она очень опасная для человеческого здоровья и снимать ее необходимо очень аккуратно – только в респираторе и перчатках.
- Чёрная – способна вызывать сильные нарушения в иммунной системе ослабленного организма человека. Она наиболее опасная из всех разновидностей домашней плесени, очень быстро разрастается, убрать довольно трудно. Обрабатывать придется особыми химическими смесями. По окончанию работ важна профилактика, дабы черный грибок не поселился на ваших стенах снова.
Какое средство от грибка выбрать?
Переходим к главному вопросу: какое средство от плесени на стенах лучше выбрать, чтобы она не проявилась со временем вновь? Вашему вниманию перечень наиболее эффективных препаратов, каждый из них прекрасно справляется со всеми типами грибка. Ваша задача- выбрать именно то средство, которое подойдет именно вам.
- Отбеливатель. Поможет очистить плесень с плитки или стекол, но не подходит для всех пористых материалов. Токсичен, поэтому использовать его нужно с особой осторожностью. Нужно развести отбеливатель водой в пропорции 1/10. Наносить лучше широкой кистью или распыляя пульверизатором.
- Уксус. Помогает бороться против плесени на всех поверхностях и материалах. Отличается резким запахом, может испортить мебель или обои, влияя на цвет. Распылите уксус или нанесите его на поверхность тряпкой. Через неделю для профилактики повторите манипуляцию.
- Сок лимона или лимонная кислота. Обладает теми же свойствами, как и уксус, но кроме этого, приятно пахнет. Обработке поддаются любые материалы, а наиболее качественно отмывается плитка. На стакан воды уходит 1 ст.л сока или кислоты. После этого производится полная обработка поверхностей.
- Перекись водорода. Оптимальное средство, так как убрать плесень этим способом удобно и безопасно. Перекись наносится на любые поверхности, кроме активно окрашенных (цвет может поблекнуть). Орудуйте тряпкой или распылителем. Через неделю заново повторите процедуру.
- Пищевая сода. Удаление плесени содой эффективно и безопасно. Столовую ложечку соды растворите в стакане воды. Распылите или разотрите по зараженному участку. Через час повторно протрите стену водой, чтобы избежать появления разводов.
- Приготовьте интересный и очень действенный раствор. Возьмите 100 мл воды, 50 мл уксуса, 50 мл перекиси водорода, 25 мл борной кислоты. Эти компоненты соедините в емкости и нагрейте на огне до 50-70 градусов. Это средство распылите или разотрите по зараженной области. Раз в пару дней повторяйте манипуляцию с целью профилактики. Данный метод является наиболее эффективным для чистки плиточных швов.
Средства и продукты, необходимые для борьбы с плесенью
Несмотря на всю опасность, которую может преподнести грибок, все-таки существует немалое количество продуктов, которые могут с легкостью навсегда удалить его с любой поверхности. Ниже представлен список этих веществ:
- Отбеливатель;
- Буры;
- Уксус;
- Аммиак;
- Перекись водорода;
- Моющее средство;
- Чайная сода;
- Масло чайного дерева;
- Экстракт семян грейпфрута.
Каждое из этих средств может помочь избавиться от грибка на любой поверхности, будь то гладкая кафельная плитка или стекло, либо пористая древесина или земля. Важно только правильно соблюсти пропорции во время приготовления раствора и грамотно нанести его на поверхность.
Смотрите также Дезинфекция квартиры против плесени
Безопасность при использовании растворов
Особое внимание, конечно же, следует уделить безопасности, потому что большинство химических растворов могут представлять опасность не только для грибков, но и для человека, поскольку имеют очень сильное воздействие на кожу, глаза и дыхательные пути. Прежде чем начать использовать сильные химические растворы, необходимо приобрести целые резиновые перчатки, сквозь которые не просочится ни малейшая капля раствора. Также нужно взять респиратор, чтобы не вдыхать эти растворы. Кроме того, будет неплохо, если на глазах будут защитные очки, так как химические испарения могут попасть на сетчатку глаза и существенно ей навредить. Ну и заключительным штрихом будет специальный костюм, который защитит от химии остальные части тела.
Как избавиться от запаха плесени
Если вы успешно справились с грибком, а запах плесени до сих пор ощущается, используйте:
- Пищевую соду. Рассыпьте тонким слоем порошок на то место, где рос грибок. Оставьте не 3-4 часа, после чего сметите или соберите пылесосом.
- Древесный уголь. Несколько емкостей с углем расставьте по периметру помещения. Уже через пару дней неприятный запах исчезнет.
- Улучшенное проветривание, ароматизаторы для дома, аэрозоли и прочие благовония. Эти средства окончательно облагородят воздух в квартире.
Как поступить, чтобы грибок не появлялся?
Если вы уже расквитались ко всеми следами налета, то следующий шаг- не допустить повторного его появления. Для этого следует изучить такие советы:
- Приобретите специализированный продукт. Наносите противомикробный спрей на те места, где находился грибок на стене в ванной или любом другом помещении. Это позволит предотвратить повторное расселение бактерий и спор. В хозяйственных магазинах продается противоплесневая краска.
- Если помещение влажное, тем самым оно наиболее уязвимое для спор, то позаботьтесь о покупке электрического обезвоживателя воздуха. Этот вариант идеален для долгосрочного избавления от черного налета.
- Обновите систему теплоизоляции в вашем жилище. Зачастую именно плохая теплоизоляция становится корнем проблемы. Если ваши стены и пол подвержены появлению конденсата, то проблема именно в нарушении теплообмена.
Как «перекрыть кислород» плесени
Верным решением проблемы является избавление от влаги, которую обожают грибки:
- Хорошенько расправляйте шторки для душа и развешивайте полотенца для просушки.
- Содержите ванную комнату, кухню и прочие влажные комнаты в чистоте и сухости. Проветривайте помещения.
- Если «грибами» покрылся стояк или слив, значит, где-то пропускает труба. Бороться с протекающими коммуникациями нужно сразу.
Опасна плесень только в том случае, когда ситуация запущена, а путь борьбы долог и труден. Вооружившись нашими советами, вы расправитесь с грибком в два счета.
Подробное описание растворов
- Продукты, содержащие в основе хлорку. Небезызвестный факт, что хлорка может убить практически любой грибок, благодаря своему химическому составу. Попадая на ровную поверхность или проникая в пористую поверхность, данный продукт остается там на некоторое время, после чего навсегда убивает грибок. Но, все же, наиболее эффективно хлористый продукт действует все-таки на гладкой поверхности, потому что в пористом покрытии он удаляет только поверхностный грибок, что касается его корней, то они по-прежнему остаются в составе пористого покрытия и впоследствии дают новые ростки;
- Не менее эффективное средство для того чтобы удалить грибок – это уксус. Данный продукт имеет очень сильную концентрацию, которая способна удалить любой грибок вплоть до самых корней. Преимущества уксуса перед хлоркой – это то, что этот продукт натуральный и нетоксичный. Из этого следует, что проветривать помещение после использования уксуса, вовсе необязательно.
Алгоритм удаления грибка с ровной поверхности:
В первую очередь, необходимо убедиться, что в помещении, где планируется дезинфекция, есть вентиляция. Поскольку продукты, содержащие хлорку, делают много выделений в воздух, после их использования необходимо будет тщательно проветрить помещение, чтобы не отравиться этими выделениями;
Для того чтобы раствор был максимально эффективным, необходимо развести один стакан продукта, содержащего хлорку на четыре литра воды. Такие пропорции помогут сделать концентрированный раствор, который сможет убить грибок до самых корней;
Наносить продукт нужно с помощью щетки или жесткой губки в большом количестве. Не стоит забывать также о резиновых перчатках, чтобы сохранить руки в безопасности.
Смотрите также Способы избавления от плесени на обоях